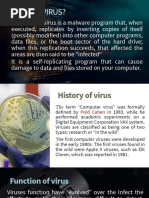

100% found this document useful (1 vote)
170 views21 pagesElectricity
This document discusses electricity and electric charges. It defines electricity as a form of energy originating from the motion of charges. Objects become charged by gaining or losing electrons - losing electrons makes them positively charged, and gaining electrons makes them negatively charged. The document explains different methods of charging, including friction, conduction, and induction. It also covers the law of conservation of charges and the fact that opposite charges attract and like charges repel.
Uploaded by
Keziah Cheluj GamengCopyright
© © All Rights Reserved
We take content rights seriously. If you suspect this is your content, claim it here.
Available Formats
Download as PPTX, PDF, TXT or read online on Scribd
100% found this document useful (1 vote)
170 views21 pagesElectricity
This document discusses electricity and electric charges. It defines electricity as a form of energy originating from the motion of charges. Objects become charged by gaining or losing electrons - losing electrons makes them positively charged, and gaining electrons makes them negatively charged. The document explains different methods of charging, including friction, conduction, and induction. It also covers the law of conservation of charges and the fact that opposite charges attract and like charges repel.
Uploaded by
Keziah Cheluj GamengCopyright
© © All Rights Reserved
We take content rights seriously. If you suspect this is your content, claim it here.
Available Formats
Download as PPTX, PDF, TXT or read online on Scribd
/ 21